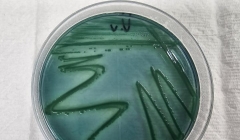

12-수성송 화가’김창수 개인전 / 사진제공=해남군 |
해남의 상징 ‘수성송(守城松)’을 20년 넘게 화폭에 담아온 김창수 화가가 오는 11월 18일부터 23일까지 해남문화예술회관 1층 전시실에서 개인전 ‘수성송과 사람들’을 연다.
이번 전시에서는 조선시대 왜구를 물리친 뒤 기념으로 심었다는 수령 500년의 곰솔 ‘수성송’을 중심으로, 해남읍성과 군민들의 삶을 예술적으로 재해석한 작품 30여 점이 공개된다.
김 화가는 오랜 세월 해남군청 앞 수성송을 꾸준히 관찰하며, 계절과 시간, 사람에 따라 변모하는 풍경을 수묵·유화·수채화 등 다양한 기법으로 표현해왔다.
그 결과 ‘수성송 화가’라는 별칭을 얻으며 지역 미술계에 독자적 세계를 구축했다.
특히 이번 전시는 ‘수성송과 사람들’을 주제로, 나무의 껍질을 갑옷처럼 묘사하고, 화면 밖으로 뻗어 나올듯한 생명력 넘치는 줄기와 함께 해남 주민, 어머니, 무명 의병 등 인물화를 결합해, 수성송이 품은 공동체의 역사와 생명력을 한 폭의 서사로 엮어냈다.
김창수 화가는 “기쁠 때나 힘들 때나 늘 그 자리를 지키는 수성송을 보며 용기를 얻었다.”며 “변화하는 시간 속에서도 변치 않는 생명의 본질을 그리고 싶었다.”고 말했다.
해남군 관계자는 “수성송은 해남의 정신이자 역사 그 자체”라며 “이번 전시가 군민 모두에게 지역의 뿌리와 정체성을 되새기는 계기가 될 것”이라고 밝혔다.
 12-수성송 화가’김창수 개인전 / 사진제공=해남군 |
[Haenam = Haenam News] haenamnews@kakao.com
“The Guardian Pine, Keeper of Haenam’s Time”
Painter Kim Chang-soo’s solo exhibition captures the life and history of Haenam through art
Kim Chang-soo, known as the “Guardian Pine Painter,” who has depicted Haenam’s symbolic pine tree Suseongsong (守城松) for over 20 years, will hold a solo exhibition titled “Suseongsong and the People” at the Haenam Culture and Arts Center from November 18 to 23.
The exhibition features about 30 works centered on Suseongsong, a 500-year-old black pine said to have been planted to commemorate the victory against Japanese invaders during the Joseon Dynasty. The artist reinterprets the life of Haenam’s citizens and the history surrounding Haenam Fortress through his distinctive artistic lens.
For two decades, Kim has observed Suseongsong in front of Haenam County Office, capturing its changing appearances across seasons, times of day, and human emotions through various techniques such as ink wash, oil, and watercolor painting. His dedication has earned him the nickname “Suseongsong Painter” and established him as a unique figure in the local art scene.
The exhibition’s central theme, “Suseongsong and the People,” presents the pine’s bark detailed like armor and its branches bursting beyond the frame with life force. These are harmoniously arranged with portraits of Haenam residents, mothers, and nameless independence fighters, symbolizing the shared spirit and vitality of a community rooted in history.
Kim stated, “Whenever I look at Suseongsong—whether in joy or hardship—I feel strength. I wanted to portray the unchanging essence of life that endures through the flow of time.”
A Haenam County official commented, “Suseongsong is not only the spirit of Haenam but its living history. This exhibition will provide residents with an opportunity to rediscover their roots and local identity.”
해남뉴스 news@hbcnews.kr
 2026.03.20 (금) 11:33
2026.03.20 (금) 11:33